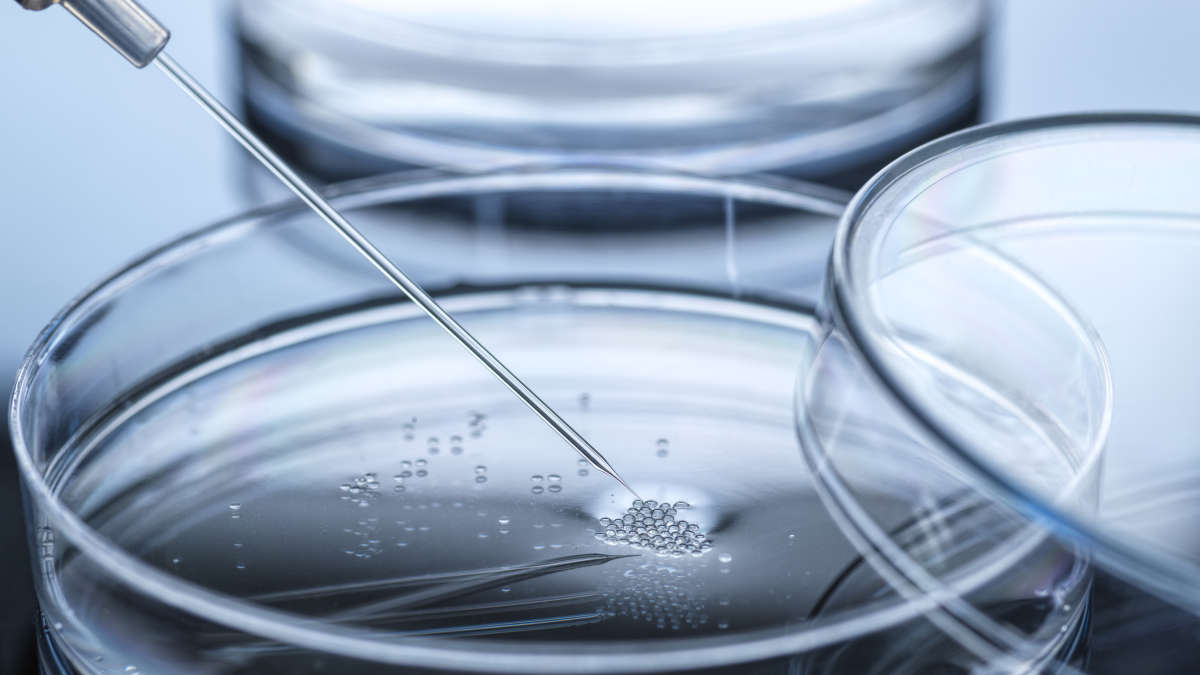
group of dividing cells

What is multiplex digital PCR?
Multiplexing in PCR enables the detection of more than one target molecule or sequence in a single reaction. Multiplexing with digital PCR (dPCR) can be achieved by varying the type of fluorophores used. In traditional multicolor multiplexing, targets are differentiated using one probe per target where the probe is conjugated with dyes of different emission spectra. Most dPCR instruments offer the detection of different fluorophores on at least two dedicated detection channels. The QIAcuity Digital PCR System, for example, enables multiplexing for clear discrimination of up to 12 targets in the same reaction.
Advantages of dPCR multiplexing
Multiplexing in dPCR has been a growing topic of interest, due to the many benefits of multiplexing with a dPCR system. The approach can be used to:
- Analyze multiple targets in a single reaction
- Reduce technical errors, such as pipetting inaccuracies
- Increase chances of target detection
- Reduce the amount of sample needed for analysis
- Provide direct internal control of an individual reaction
- Save time and reagents to reduce overall cost
Multiplexing with digital PCR enables several applications that are not possible or easy to perform using single-color assays. Some of these analyses include:
- Copy number variants: With a duplex approach, pairing of target and reference genes to determine their ratio
- Biallelic variation of single nucleotide variants or small insertions/deletions: Duplex approach with two hydrolysis probes, visualized using two color plots (1)
- Genotyping: Counting partition numbers from single and double positive clusters (1)
A digital PCR instrument with high multiplexing power makes it possible for you to analyze multiple targets in one sample with high sensitivity and reproducibility. For example, the QIAcuity Digital PCR System exists in several configurations to fit your need for sample and target analysis.
The nanoplate digital PCR advantage for multiplex reactions
Multiplex digital PCR is a preferred approach, because the method is more flexible, sensitive and specific than multiplex qPCR. Multiplexing by qPCR might also require more complicated methods for calculating absolute values and the method is more susceptible to interference of multiple PCRs in one reaction. With software features, such as a custom cross-talk matrix, you can address cross-talk signals between neighboring channels based on your assay and run parameters. This helps to further increase your dPCR multiplex capacity and data accuracy compared to qPCR.
Nanoplate digital PCR offers distinct advantages over other types of digital PCR, including short run times, high precision and sensitivity and high-order multiplexing options, including amplitude multiplexing.
The QIAcuity instrument offers six colors which can be used for target detection in six channels plus two hybrid channels. These hybrid channels are used for Long Stokes-Shift (LSS) dyes. How do these dyes work? The spectral shift between the absorbed light and the emitted light in LSS dyes is longer compared to standard fluorescence dyes. This means absorption and emission are handled with different channels – for example, the excitation happens with the wavelength of the standard green channel, but the emission/image acquisition is achieved with the yellow filter. This facilitates analysis of up to 8-plex reactions.
For even more targets, you can try high-order multiplexing. With the possibility of amplitude multiplexing on the QIAcuity, using the QIAcuity High Multiplex Probe PCR Kit, you can analyze up to 12 targets. Amplitude multiplexing simultaneously quantifies two targets in the same color channel, effectively doubling the data output per reaction. The QIAcuity software (version 3.1 and later) supports amplitude multiplexing by introducing three adjustable thresholds within the channel to distinguish between target one, target two and double positives. With these thresholds, you can analyze each target’s amplification in the sample.
Advanced high-order multiplexing capabilities optimize laboratory resources and provide a high-resolution view of genetic variations. These features are critical for applications such as copy number variation and microbial detection, in particular when samples are limited.
How amplitude multiplexing works on the QIAcuity
Key features of the QIAcuity family
High-throughput and multiplexing features of the QIAcuity* Digital PCR System for non-clinical research use and the QIAcuityDx** Digital PCR System for in vitro diagnostic use
| QIAcuity* One 2plex | QIAcuity* One 5plex | QIAcuity* Four | QIAcuity* Eight | QIAcuityDx** Four | |
|---|---|---|---|---|---|
|
Detection channels |
2 | 8a (6+2 hybridb) |
8a |
8a |
5 |
| Multiplexing capability | 4 | 12c,a | 12c,a | 12c,a | 5 |
|
Number of samples |
Up to 480 |
Up to 480 |
Up to 768 |
Up to 1536 |
Up to 768 (96-well)d Up to 192 (24-well) |
| Purpose | Non-clinical applications | IVD applications | |||
Got a few more introductory questions on dPCR multiplexing? See if our QIAgenius can tackle them:
Applications of multiplex dPCR
Considerations for accurate quantification with multiplex digital PCR
- Optimize individual assays: Validate individual reactions prior to dPCR multiplexing (for example, check for occurrence of dimers)
- Assess primers and probes: Check for potential interaction between your primers and probes
- Carefully select dyes: Choose dyes for each assay carefully; select dyes with a bright fluorophore for low copy targets
- Check for linked targets: Investigate potential for linked targets or higher-order target correlations; for example, use linkage-based assays to measure cis versus trans configuration of targets and potential structural rearrangements
- Avoid cross hybridization: If possible, design probe-to-target variations involving two or more nucleotide deletions or insertions to avoid probe mismatches
- Minimize optical bleedthrough: Occurs if the fluorescence from a dye is picked up by more than one channel; if possible, try to make sure your conjugated dyes match the optical detection systems or adjust signal processing parameters in the analysis software
- Address cross-talk issues: Check if your system has specialized software features, such as a custom cross-talk matrix, which can help analyze cross talk between neighboring channels for all multiplex assays and increase the confidence in your data
- Reduce presence of rain: Rain describes the subset of partitions that are higher than the negative but lower than the positive partitions. You can reduce rain by re-assessing your template type, confirmation, integrity, assay specificity and presence of inhibitors in the reaction; consider setting the threshold position differently to avoid influence from rain on quantification
Getting started with multiplex dPCR
If you are interested in performing multiplex digital PCR, consider investing in a dPCR instrument with advanced multiplexing capabilities. There are also numerous dPCR kits and dPCR assays developed for multiplex digital PCR assays that could bring multiple benefits to both beginners and experts of multiplexing.
- Your digital PCR instrument – There are many types of digital PCR systems available, but some offer more multiplexing options than others. With the QIAcuity dPCR system, you can set up 8-plex assays by multiplexing in up to six standard channels and two hybrid channels for LSS dyes. If you use the standard channels for amplitude multiplexing, you can increase the multiplexing capabilities of the QIAcuity to 12plex.
| Channel | Excitation (nm) | Emission (nm) | Example fluorophores |
|---|---|---|---|
|
Green |
463 – 503 |
519 – 549 |
FAM™, EvaGreen® |
|
Yellow |
513–534 |
551–565 |
HEX™, VIC® |
|
Orange |
541–563 |
582–608 |
TAMRA™, Atto 550 |
|
Red |
568–594 |
613–655 |
ROX™, Texas Red® |
|
Crimson |
588–638 |
656–694 |
Cy5®, Quasar 680 |
|
Far red |
651-690 |
709-759 |
Cy5.5, Atto 680, Atto 700 |
|
Green / Yellow |
463–503 |
551–565 |
DY-482XL (LSS G/Y)* |
|
Orange / Red |
541–563 |
613–655 |
DY-540XL (LSS O/R)* |
- Your multipurpose dPCR kits – Consider using dPCR kits developed for multiplex reactions. The QIAcuity High Multiplex Probe PCR Kit is ideal for challenging samples and multiplexing beyond five targets. The QIAcuity Probe PCR Kits include special master mixes to quantify up to five targets with widely differing abundance on a QIAcuity Nanoplate. dPCR multiplexing saves you time, costs and sample material without affecting data quality or validity.
- dPCR kits for contamination-free analysis – Specialized kits exist for applications that require ultra-clean master mixes that minimize contaminating background DNA. The QIAcuity UCP Probe PCR Kit is ideal for microbial analysis or for quality control applications, such as residual DNA testing. The kits offer high specificity and accuracy in quantifying gDNA or cDNA in singleplex or 5-plex dPCR assays.
- Application-specific dPCR multiplex assays – To increase throughput and reduce costs according to specific applications, dPCR assays with different dyes (FAM, HEX, ROX, Atto 500 and Cy5) have been developed. These multiplex dPCR assays enable flexible experimental design and multiplex analysis of up to five targets in one reaction. Specific dPCR assays are available for CNV analysis, microbial detection, cell and gene therapy and LNA mutation assays for cancer-related mutations.
Featured products for multiplex digital PCR
Publications with dPCR multiplexing
More resources on mutliplex dPCR
Further References
- Whale AS, Huggett JF, Tzonev S. Fundamentals of multiplexing with digital PCR. Biomolecular Detection and Quantification. 2016; 10:15–23.
- Izadpanah M et al. Simple and fast multiplex PCR method for detection of species origin in meat products. Journal of Food Science and Technology. 2017; 55(2): 698–703.
- Lee YM, Lee S, Kim HY. A multiplex PCR assay combined with capillary electrophoresis for the simultaneous identification of Atlantic cod, Pacific cod, blue whiting, haddock, and Alaska pollock. Foods. 2021; 10(11):2631.
- Pecoraro S et al. Overview and recommendations for the application of digital PCR. EUR 29673 EN, Publications Office of the European Union, Luxembourg, 2019. https://gmo-crl.jrc.ec.europa.eu/doc/WG-dPCR-Report.pdf.
- Dobnik D, Spilsberg B, Bogožalec K, Holst-Jensen A and Žel J. Multiplex quantification of 12 European Union authorized genetically modified maize lines with droplet digital polymerase chain reaction. Analytical Chemistry. 2015; 87(16):8218–8226.
- Lao TD, Le TAH. Exploring the multiplex PCR for detection of animal-derived ingredients in vegetarian foods. Pharmacopore. 2020; 3.
- Boukharouba A, González A., García-Ferrús M., Ferrús A. Botella S. Simultaneous detection of four main foodborne pathogens in ready-to-eat-food by using a simple and rapid multiplex PCR (mPCR) assay. International Journal of Environmental Research and Public Health. 2022; 19(3): 1031.
- Appay R et al. Multiplexed droplet digital PCR assays for the simultaneous screening of major genetic alterations in tumors of the central nervous system. Frontiers in Oncology. 2020; 10:579762.
- Peitz C et al. Multiplexed quantification of four neuroblastoma DNA targets in a single droplet digital PCR reaction. Journal of Molecular Diagnostics. 2020; 22(11):1309–1323.
- Jiang L et al. Development and validation of a 4-color multiplexing spinal muscular atrophy (SMA) genotyping assay on a novel integrated digital PCR instrument. Scientific Reports. 2020; 10: 19892.
- Oscorbin I, Kechin A, Boyarskikh U., Filipenko M. Multiplex ddPCR assay for screening copy number variations in BRCA1 gene. Breast Cancer Research and Treatment. 2019; 178(3):545–555.
- Hughesman CB et al. A robust protocol for using multiplexed droplet digital PCR to quantify somatic copy number alterations in clinical tissue specimens. PLOS ONE. 2016; 11(8): e0161274
- Yu Q. et al. Multiplex picoliter-droplet digital PCR for quantitative assessment of EGFR mutations in circulating cell-free DNA derived from advanced non-small cell lung cancer patients. Molecular Medicine Reports. 2017; 16(2):1157–1166.
- Andersen RF And Jakobsen A. Screening for circulating RAS/RAF mutations by multiplex digital PCR. Clinica Chimica Acta. 2016; 458:138–143.
- Corné J et al. Development of multiplex digital PCR assays for the detection of PIK3CA mutations in the plasma of metastatic breast cancer patients. Scientific Reports. 2021; 11(1):17316.
- Dong L et al. A rapid multiplex assay of human malaria parasites by digital PCR. Clinica Chimica Acta. 2023; 539:70–78.
- Shi K et al. A multiplex crystal digital PCR for detection of African Swine Fever Virus, Classical Swine Fever Virus, and Porcine Reproductive and Respiratory Syndrome Virus. Frontiers in Veterinary Science. 2022; 9:926881.
- Wu, J et al. Clinical validation of a multiplex droplet digital PCR for diagnosing suspected bloodstream infections in ICU practice: a promising diagnostic tool. Crit Care. 2022; 26: 243.
- Zhu X et al. Development of a multiplex droplet digital PCR assay for detection of enterovirus, parechovirus, herpes simplex virus 1 and 2 simultaneously for diagnosis of viral CNS infections. Virology Journal. 2022; 19:70.
- Maggi R, Breitschwerdt EB, Qurollo B, Miller JC. Development of a multiplex droplet digital PCR assay for the detection of Babesia, Bartonella, and Borrelia species. Pathogens 2021; 10(11):1462.
- Shin J et al. Duplex dPCR system for rapid identification of gram-negative pathogens in the blood of patients with bloodstream infection: A culture-independent approach. Journal of Microbiology and Biotechnology. 2021; 31(11):1481–1489.
- Te SH, Chen EY, Gin KYH. Comparison of Quantitative PCR and Droplet Digital PCR Multiplex Assays for Two Genera of Bloom-Forming Cyanobacteria Cylindrospermopsis and Microcystis. Applied and Environmental Microbiology. 2015; 81(15):5203–5211.
- Hayes D and Dobnik D. Commentary: Multiplex dPCR and SV-AUC are promising assays to robustly monitor the critical quality attribute of AAV drug product integrity. Journal of Pharmaceutical Sciences 111(8): 2143–2148.
- Nell RJ et al. Accurate quantification of T Cells in copy number stable and unstable DNA samples using multiplex digital PCR. Journal of Molecular Diagnostics. 2022; 24(1):88–100.
- Sanchez MEN et al. Multiplex reverse transcriptase droplet digital PCR for the simultaneous quantification of four dengue serotypes: Proof of concept study.2020; Biologicals 67:62–68.
- Meng P et al. Development of a multiplex dPCR assay for ERBB2 amplification in breast cancer. European Journal of Cancer. 2022; 175(1):S80.
- Morisset D, Štebih D, Milavec M, Gruden K, Žel J. Quantitative analysis of food and feed samples with droplet digital PCR. PLoS One. 2013; 8(5): e62583.
- Oscorbin IP et al. Multiplex droplet digital PCR assay for detection of MET and HER2 genes amplification in non-small cell lung cancer. Cancers (Basel). 2022; 14(6):1458.
- Center for Breakthrough Medicines. https://breakthroughmedicines.com/all/tech-note-high-throughput-aav-viral-titering-using-nanoplate-based-digital-pcr/ (Accessed April 21, 2023)